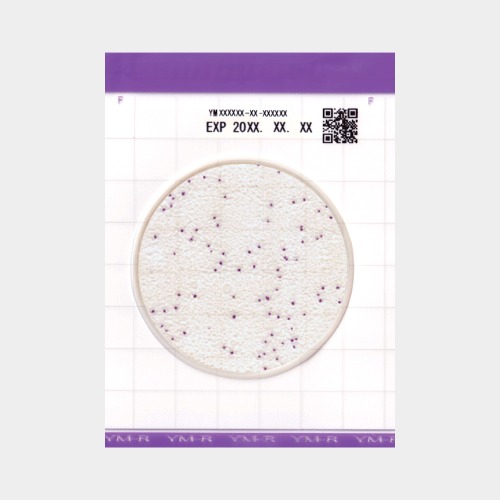
이지플레이트 효모곰팡이 YM 건조배지 필름메디아 38,500원

이지플레이트 대장균군 CC 건조배지 필름메디아 가격 분석 리포트
2026년 4월 10일 기준, 이 상품의 가격은 25,300원입니다. roochas가 지난 3일간 추적한 데이터를 기준으로, 역대 최저가는 25,300원이며 지금이 역대 최저가와 동일한 수준입니다. 평균 거래가 25,300원과 비교하면 현재 평균가보다 높은 가격대에 위치해 있습니다.
가격 변동성 분석
3일간 최저 25,300원에서 최고 25,300원까지, 가격 변동폭은 0원이며 변동률은 0%로 안정 수준입니다. 최근 가격 추세는 보합세를 보이고 있습니다.
AI 구매 타이밍 판단
roochas AI가 분석한 현재 구매 타이밍은 “최적”입니다. 역대 최저가 수준으로 3일간 데이터 분석 결과 지금이 가장 유리한 구매 시점입니다. 실시간 가격 변동 알림을 통해 최적의 구매 시점을 놓치지 마세요.